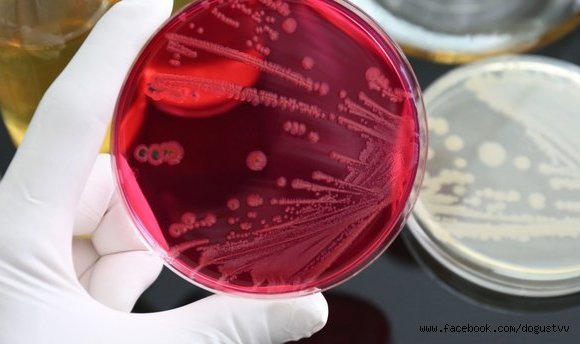
NİJERYA'DA GİZEMLİ HASTALIK

Nijerya'da "teşhis edilemeyen hastalık" ülkeyi alarma geçirdi.Kaduna eyaletindeki Sir Patrick Yakowa Hastanesi Sekreteri Ezra Joshua, yaptığı açıklamada, eyaletin Kafanchan bölgesindeki henüz teşhis edilemeyen hastalık nedeniyle 5 kişinin öldüğünü, 10 kişinin hastanelik olduğunu belirtti.Joshua, hayatını kaybeden kişinin ölüm nedenine ilişkin araştırmaların sürdüğünü ifade ederek, hastaneye getirilenlerin bazılarında öksürük ve kusma görüldüğünü kaydetti. Ebeveynleri çocuklarını yerel doktorlara yönlendirmekten vazgeçmeleri konusunda uyaran Joshua, herhangi bir hastalık belirtisi gördüklerinde onları hızla hastaneye sevk etmeleri çağrısında bulundu.
Güncel
Yayınlanma: 24 Temmuz 2023 - 15:19
NİJERYA'DA GİZEMLİ HASTALIK
Nijerya'nın Kaduna eyaletinde "teşhis edilemeyen hastalık" nedeniyle 5 kişi yaşamını yitirdi
Güncel
24 Temmuz 2023 - 15:19
EDİTÖR
İlginizi Çekebilir